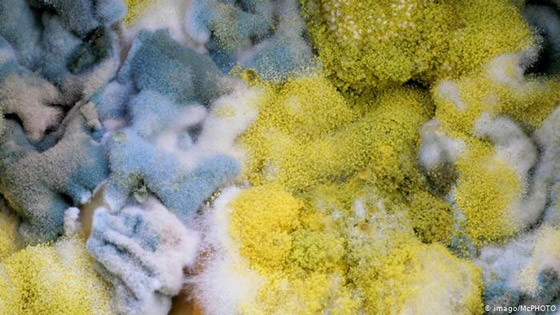

تعيش الجراثيم في أنواع مختلفة من الطعام، وتتسبب في أمراض ومضاعفات خطيرة على الصحة قد تصل في بعض الأحيان إلى حد الموت. ألبوم الصور التالي، يسلط الضوء على أبرز أسباب انتشار هذا "العدو الخفي" وكيف يمكن الحماية منه؟

الأفلاتوكسين - سم الفطر
الأفلاتوكسينات هي سموم طبيعية تتكون من أنواع مختلفة من الرشاشية (نوع من الفطر). ويزدهر العفن الفطري بشكل خاص في المناطق المدارية وشبه المدارية. وتعتبر المكسرات والبذور والحبوب والذرة من الأكثر تضرراً من هذه السموم، مما يؤدي إلى تدمير 25 في المائة من المحاصيل كل عام، حسب منظمة الصحة العالمية.
عفن فطري قاتل
يمكن لكميات صغيرة من الأفلاتوكسين أن تؤدي إلى سرطان الكبد وتشوهات في الرحم. أما كميات أكبر من هذا السم، فقد تتسبب في الإصابة بتسمم حاد في الكبد أو حتى الموت. كما أن الطبخ لا يعني القضاء بالمرة على السموم. لذلك، من الضروري دائماً فحص الأطعمة جيداً بحثاً عن العفن.

بكتيريا السالمونيلا
السالمونيلا هي بكتيريا موجودة في الجهاز الهضمي لدى العديد من الحيوانات. وغالباً ما تكون العدوى من دون أعراض. ويصاب الطعام بالتلوث خاصة عندما لا يتم الوفاء بمعايير النظافة، إذ لا يؤثر هذا فقط على الدجاج والبيض (تنتقل بسهولة بينها) بل أيضاً على بعض الأطعمة على غرار: شاي الأعشاب أو حبوب السمسم. ويساعد الطبخ على التخلص من البكتيريا، التي لا تحب الحرارة على الإطلاق.

الإشريكية القولونية و "EHEC"
الإشريكية القولونية هي بكتيريا معوية تلعب أدواراً جد مهمة في الجسم. بيد أن الأشخاص الذين يعانون من ضعف الجهاز المناعي، قد يصابون بعدوى مختلفة بسبب الإشريكية القولونية. أما الأخطر فهي بكتيريا "EHEC"، فبكتيريا القولون هذه تنتج السموم، التي تسبب التهاب الأمعاء.

الآن لدينا سلطة
مثل بكتيريا السالمونيلا يمكن القضاء على بكتيريا "Kolibakterien" عن طريق الحرارة. غير أنها يمكن للبكتيريا أن تصيب أيضاً الخس أو الخيار. والخضراوات التي يتم تناولها نيئة يجب أن تكون طازجة قدر الإمكان من أجل صحة أفضل.

الليستيريا: نادرة لكنها خطيرة
الليستيريا هي بكتيريا قابلة للتكيف بشكل كبير للغاية، وتظهر في كل مكان تقريباً ومن بينها طعامنا. وفي حال ظهور الليستيريا في الجسم، فقد تؤدي إلى تسمم الدم أو التهاب السحايا، خاصة لدى كبار السن والأطفال الصغار. ويمكن القضاء على هذه البكتيريا عن طريق الحرارة.

ليست فقط بكتيريا
يعد النوروفيروس (فيروس) من أحد الأسباب الأكثر شيوعاً للتقيؤ والإسهال. وكما هو الحال مع باقي أنواع البكتيريا، يعتبر الافتقار إلى النظافة هو المدخل الرئيسي للبكتيريا من أجل الوصول إلى الأغذية. وتستطيع البكتيريا البقاء 12 يوماً على قيد الحياة في الخضراوات واللحوم. لهذا السبب، يجب غسل اليدين جيداً بالإضافة إلى الحرارة (الطبخ).

غسل الأيدي
يمكن للمواد الغذائية أن تتلوث أثناء عملية إنتاجها. كما يمكن أن يقع هذا التلوث في منازلنا. إلاّ أنه قبل وقوع هذا نستطيع حماية أنفسنا جيداً من خلال اتباع بعض قواعد النظافة البسيطة. والقاعدة الأهم هي غسل الأيدي قبل عملية طهو الطعام.

القاعد الذهبية للنظافة
بالنسبة للحوم النيئة، يجب استخدام سكاكين وألواح تقطيع أخرى لا تستعمل في تقطيع وتحضير الخضراوات النيئة. بالإضافة إلى ذلك، يجب أن يتم فصل الأطعمة المجمدة عن باقي الأطعمة الأخرى عند شرائها في السوبر ماركت، وكذلك طهي اللحوم والأسماك لمدة 10 دقائق على الأقل وعلى درجة حرارة 70 مئوية ثم تناولها بسرعة.